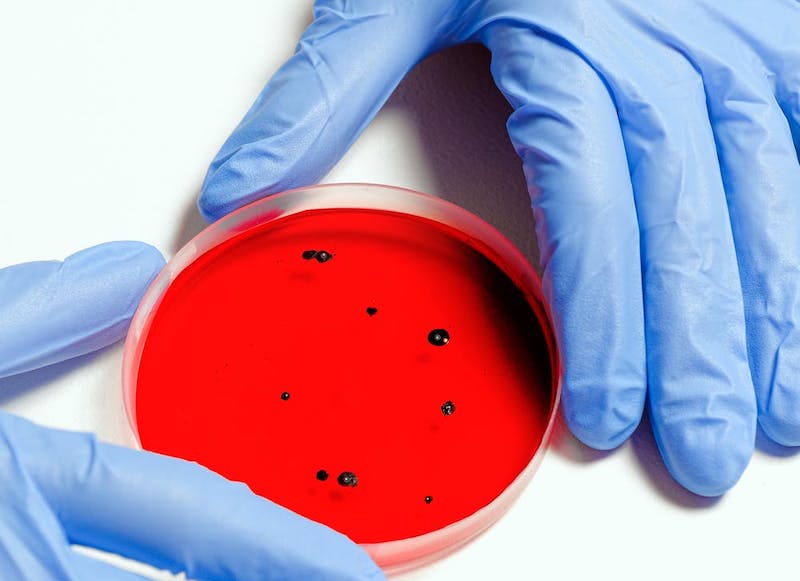

Lefoglalt vakcinák – Vakrepülés, de nincs más
10/08/2020 08:51
| Szerző: Klubrádió/K.K.
Komoly kockázatot vállalnak a tagországok, sőt az egész Európai Unió, amikor a koronavírus elleni vakcina kifejlesztését támogatják, és egyetlen céget preferálnak.
Ötmillió adag vakcinát foglalt le Magyarország, hogy mielőbb elkezdődhessen a koronavírus elleni tömeges oltás. Csakhogy vakcina még nincs. Akkor minek a lefoglalását jelentette be Orbán Viktor?
Ferenci Tamás, az Óbudai Egyetem docense, orvosbiológiai mérnök, biostatisztikus mondta el, hogy valójában mi történik. Az országok „ölni fognak” az oltóanyagért, ha egyszer elkészül. Az Európai Bizottság megpróbál a harc elé menni, ezért lekötött 300 millió koronavírus elleni vakcinát a francia Sanofi gyógyszergyártónál. A fejlesztés ott már olyan fázisban van, hogy szeptemberben indulhat a tesztelés, jövő nyáron már kapható lesz az oltóanyag, ha igaz. Azonban egyelőre nem tudni, hogy működik-e, elkészül-e időre, és még számtalan más kérdésre sincs válasz. Arra sem, hogy ez lesz-e a jó, vagy valamelyik másik, hiszen 3-4 fejlesztés tart hasonló stádiumban.
Vakrepülés az egész, ráadásul az EB pénzzel is támogatja a gyártást. Nem lehet mást tenni – mondja Ferenci Tamás. Ez még mindig jobb megoldás, mint amit az angolok csinálnak. Ott ugyanis gyakorlatilag gyártósorok készülnek, üzemek épülnek olyasvalaminek a gyártására, ami még nincs. Az EU-ban egyelőre csak besorakoztak az országok a vevők sorába.
Hogy mi a helyzet a második hullámmal, az is kérés. A tavaszi szigor enyhítésével törvényszerűen jár együtt a fertőzések számának emelkedése. Az lenne a furcsa, ha nem így lenne. Magyarországon még jobb a helyzet, mint a szomszédos országokban, hogy miért, arra nincs pontos magyarázat. Érdemes lelkileg felkészülni arra, hogy ez a jó, vagy szerencsés helyzet megváltozhat.
Az interjút a fenti lejátszóra kattintva hallgathatja meg. Kiemelt kép: MTI/Sóki Tamás.
2020.08.10.06:00
Műsorvezető: Szénási Sándor
